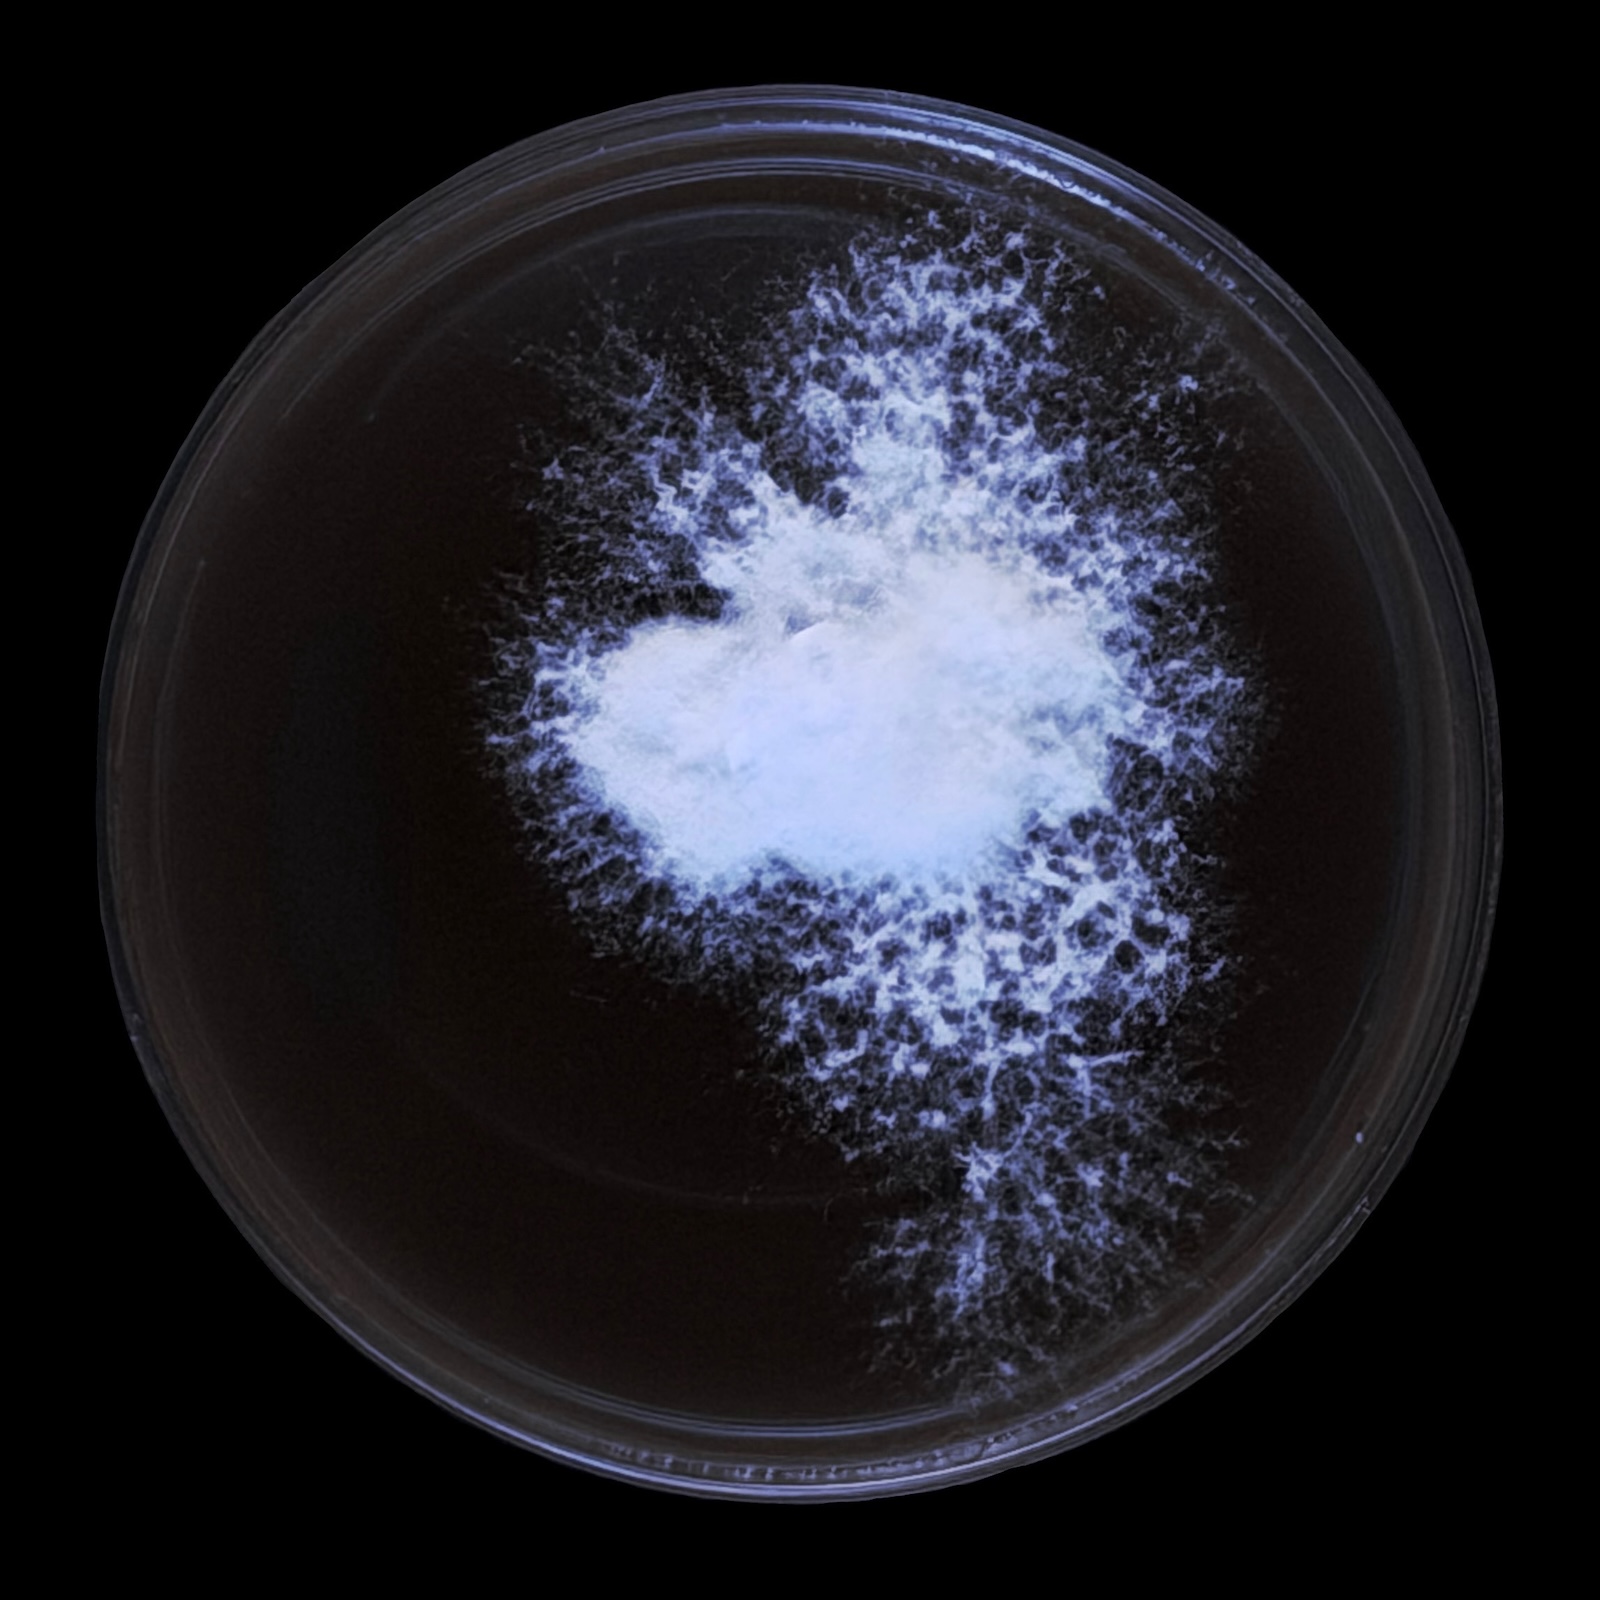
Black Oyster petri dish
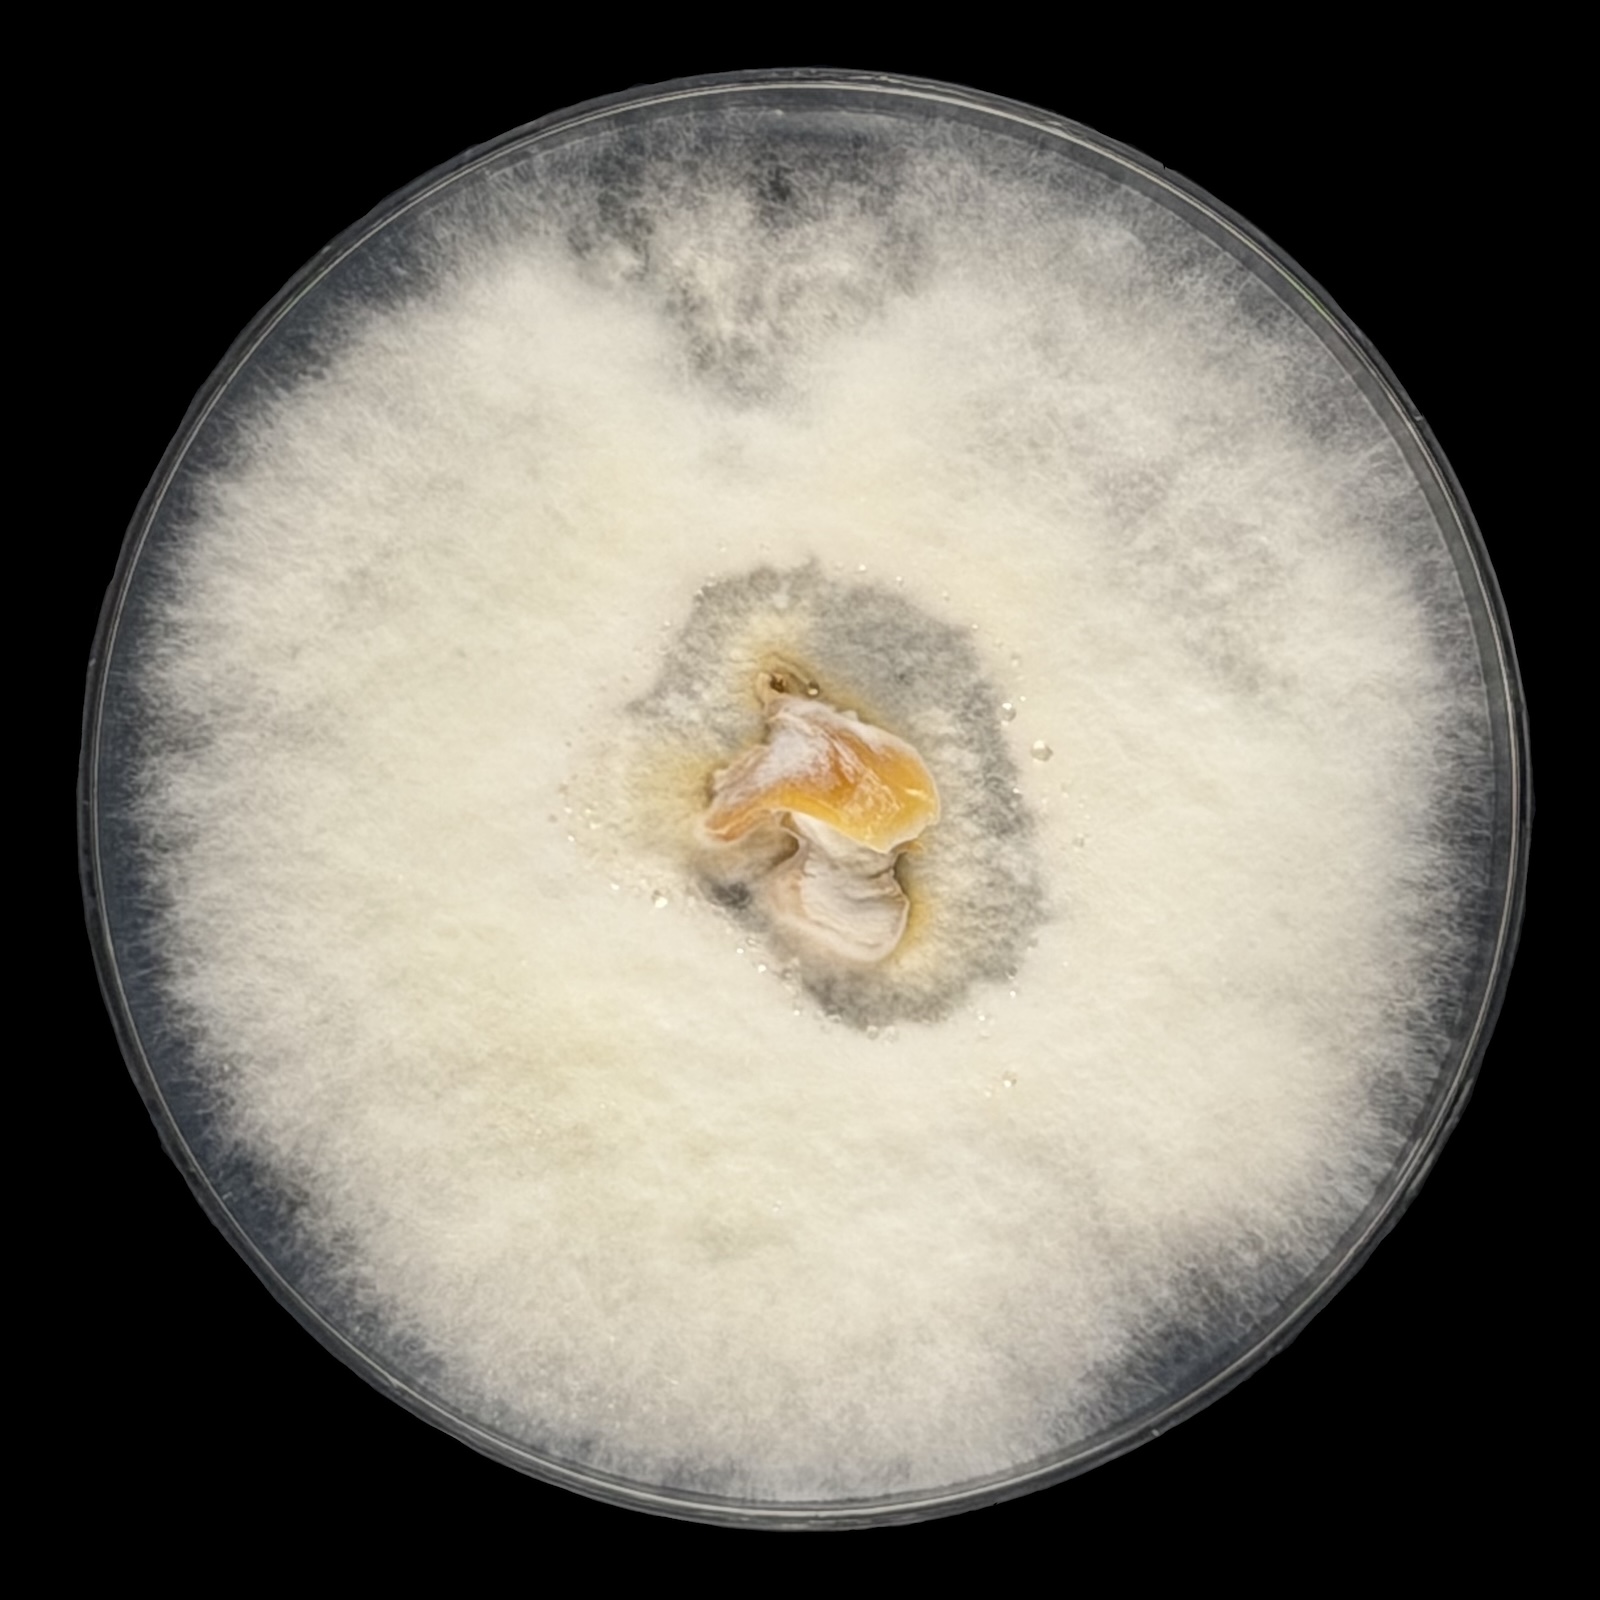
Shiitake Day 28

Kenji steps off the train in Sapporo.
Everything is new, overwhelming, beautiful.
He’s left behind his old life—the corporate cultivation facility, the endless cycles, the exhaustion.
He doesn’t know anyone.
He doesn’t know what comes next.
But for the first time in years, he feels something like hope.
ケンジは札幌で電車を降りた。
すべてが新しく、圧倒的で、美しかった。
古い生活は置いてきた——企業の栽培施設、終わりのないサイクル、そして疲労。
誰も知らない。
次に何が来るかもわからない。
でも、何年かぶりに、希望のようなものを感じていた。
 「ご存知だったかな?」Did you know? — Reiji Hakase
「ご存知だったかな?」Did you know? — Reiji Hakase

When a spore lands in a new place, it doesn’t know if the substrate will welcome it.
It sends out a single hypha—a thread of hope—and waits to see what connects.
胞子が新しい場所に降り立った時、その基質が自分を受け入れるかどうかなど、知る由もない。
それでも一本の菌糸——いわば希望の糸——を伸ばし、何とつながるかを待つのである。
🔬 Weekly Spore Report · 週刊胞子レポート

This one is ours, started as a grocery store mushroom from Aeon. Cut, plated on January 29, 2026 in the Studio.
これは私たちの椎茸です。イオンで買った椎茸から始めました。2026年1月29日、スタジオにてカット、寒天培地にプレーティング。